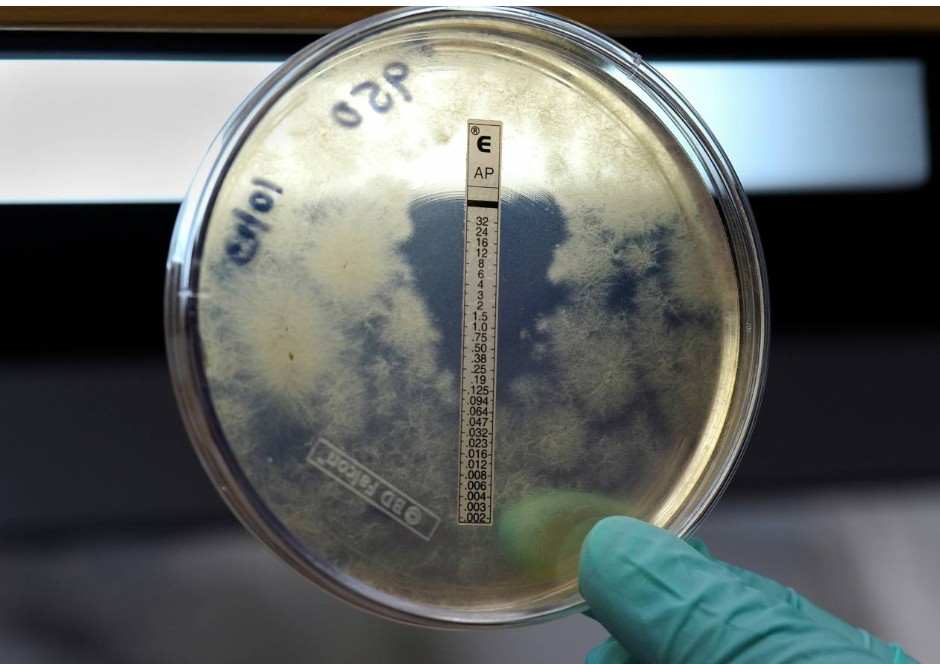

Un evento de superpropagación en jóvenes británicos con dos fallecidos ha reavivado la alarma ante una enfermedad poco frecuente pero potencialmente mortal. En España, donde la incidencia sigue siendo baja, los expertos recuerdan que la vacunación, la detección precoz y la vigilancia epidemiológica son claves para su control
Por: Aser G. Rada | Agencia SINC
El reciente brote de enfermedad meningocócica en el condado de Kent, en el Reino Unido, ha puesto en alerta a las autoridades sanitarias británicas y europeas. El episodio, que afectó principalmente a estudiantes y se asoció al contacto estrecho entre jóvenes en una discoteca de Canterbury entre el 5 y el 7 de marzo y en el entorno universitario de la Universidad de Kent, ha provocado alrededor de tres decenas de casos y dos fallecimientos.
Como se confirmó posteriormente, el brote estuvo causado por el meningococo del grupo B (MenB), una de las variantes más frecuentes en Europa. La rápida aparición de múltiples casos en un corto periodo llevó a desplegar medidas intensivas de salud pública, como la administración preventiva de antibióticos a miles de contactos y campañas de vigilancia epidemiológica.
Aunque las autoridades sanitarias británicas consideran que el pico del brote podría haber pasado y el Centro Europeo para la Prevención y el Control de Enfermedades (ECDC) estima muy baja la probabilidad de expansión internacional —solo Francia ha notificado un caso posiblemente vinculado—, la Agencia de Seguridad Sanitaria del Reino Unido (UKHSA) ha descrito el episodio como “inusual” por su magnitud y velocidad.
Contacto estrecho y ambientes cerrados
Según desgrana en The BMJ la especialista en enfermedades infecciosas Eliza Gil, profesora de la London School of Hygiene and Tropical Medicine, estas características podrían explicarse por una combinación de factores poco habituales, dado que la transmisión del meningococo (que requiere contacto estrecho) suele producir solo colonización sin enfermedad: se puede portar la bacteria en la garganta sin presentar síntoma alguno.
Sin embargo, en determinadas circunstancias pueden producirse los llamados eventos de superpropagación o supercontagio. Gil señala que, en este caso, una posible explicación es que una persona portadora con una alta carga bacteriana transmitiera una cepa particularmente transmisible en un entorno cerrado y concurrido. “Una combinación de circunstancias desafortunadas”, como la falta de inmunidad en los asistentes y la intensa interacción social, habría facilitado la expansión posterior en redes sociales densamente conectadas, como residencias universitarias.
A ello podría sumarse la aparición de una variante genética distinta. Investigaciones preliminares difundidas por la UKHSA el 23 de marzo apuntan a que el brote está causado por un subtipo relativamente reciente del meningococo B que presenta múltiples diferencias genéticas respecto a cepas cercanas. Según la agencia, “estas diferencias deben evaluarse para entender cómo podrían modificar el comportamiento de la bacteria”.
Diego García, microbiólogo del Hospital Universitario Nuestra Señora de Candelaria, en Tenerife, y portavoz de la Sociedad Española de Enfermedades Infecciosas y Microbiología Clínica (SEIMC), coincide en que la magnitud del brote responde probablemente a la concurrencia de varios factores. “Hace falta que se junten circunstancias concretas: contacto estrecho, ambientes cerrados y, posiblemente, alguna particularidad genética de la cepa”, recalca por teléfono a SINC.
Poco común, pero potencialmente letal
La meningitis es una inflamación de las meninges, las membranas que rodean el cerebro y la médula espinal. Puede estar causada por virus, bacterias u otros microorganismos, pero las formas bacterianas son las más graves.
Entre ellas destaca la causada por la bacteria Neisseria meningitidis, también llamada meningococo, responsable de la denominada enfermedad meningocócica invasiva (EMI), una infección aguda potencialmente mortal. Esta enfermedad puede presentarse como meningitis meningocócica, sepsis meningocócica —cuando la bacteria invade el torrente sanguíneo y puede afectar a múltiples órganos— o una combinación de ambas.
Como explica García, la sepsis meningocócica suele evolucionar con especial rapidez y puede manifestarse con fiebre alta, malestar general, somnolencia o confusión, además de la aparición de manchas rojizas en la piel que no desaparecen al presionarlas (conocidas como petequias), un signo característico de los cuadros más graves. Una de cada cinco infecciones meningocócicas se presenta en forma de sepsis, que suele tener peor pronóstico que la meningitis aislada.
Incluso con tratamiento adecuado, la letalidad global de la EMI puede situarse entre el 8 % y el 15 %. De hecho, un análisis que se publica hoy en The Lancet Neurology revela que, en 2023, 259 000 personas murieron a causa de la meningitis en todo el mundo y 2,5 millones de personas se infectaron con la enfermedad. De esos fallecimientos, más de un tercio fueron menores de cinco años.
Según el estudio, aunque las tasas de mortalidad e infección han disminuido significativamente desde 1990, la carga de la enfermedad sigue siendo muy alta en países de bajos ingresos, especialmente en Nigeria, Chad y Níger.
Además, un porcentaje significativo de supervivientes puede presentar secuelas permanentes. Dado que el deterioro clínico puede producirse en cuestión de horas, el diagnóstico precoz y el tratamiento inmediato son determinantes para la supervivencia.
Vacunación y prevención
Existen varios serogrupos de meningococo —entre ellos A, B, C, W e Y—, siendo los B y C los más frecuentes en los países occidentales, incluida España.
El periodo de incubación oscila entre dos y diez días, aunque lo habitual es que los síntomas aparezcan entre tres y cuatro tras el contagio. La transmisión requiere contacto estrecho y prolongado con secreciones respiratorias, como ocurre al besar, compartir bebidas o convivir en espacios cerrados.
Sin embargo, como recuerda García, no se propaga con la facilidad de otros patógenos respiratorios, como el sarampión, y solo una pequeña proporción de las personas que entran en contacto con la bacteria desarrolla infecciones graves. “Aproximadamente un 10 % de la población es portadora, pero no sabemos exactamente por qué algunas personas desarrollan enfermedad invasiva y otras no; probablemente influyen factores inmunológicos y genéticos que aún se están investigando”, aclara el experto.
La principal herramienta preventiva frente a la enfermedad meningocócica es la vacunación, añade. Como recuerda en un comunicado la Asociación Española de Pediatría (AEP), los grupos con mayor riesgo son los niños pequeños y los adolescentes y adultos jóvenes, en parte por sus patrones de interacción social. Por ello, su Comité Asesor de Vacunas recomienda la inmunización frente al meningococo B de forma sistemática en lactantes desde los dos meses de edad y una dosis en la adolescencia —como ya recogen los calendarios vacunales de las comunidades autónomas—, además de recuperar a quienes no hayan completado la pauta.
En España: vigilancia e información
En nuestro país, el calendario vacunal infantil incluye inmunización frente a varios serogrupos del meningococo además del B.
En etapas posteriores de la vida, cuando la EMI es menos frecuente, la vacunación se dirige principalmente a grupos de riesgo, como personas con determinadas inmunodeficiencias que aumentan la susceptibilidad.
En gran parte gracias a una alta cobertura vacunal, en España —al igual que en el Reino Unido— la incidencia de EMI sigue siendo baja. En 2024 se notificaron 348 casos, una cifra superior a la registrada durante los años de pandemia, pero similar a la observada antes de 2020, según el Ministerio de Sanidad. La mayoría de ellos fueron causados por el serogrupo B, seguido por los serogrupos W e Y.
Pero el brote británico ha tenido también consecuencias en el ámbito informativo. Según explican a SINC fuentes de la Secretaría de Estado de Comunicación, que monitoriza tendencias de desinformación en entornos digitales mediante herramientas basadas en inteligencia artificial, se ha detectado un incremento de contenidos inexactos o descontextualizados relacionados con la meningitis tras el mismo, especialmente en redes sociales.
La experiencia previa indica que la difusión temprana de información oficial clara y veraz contribuye a reducir la propagación de rumores y mensajes erróneos, explican las mismas fuentes. Por ello, en este contexto, el Ministerio de Sanidad difundió recientemente un comunicado dirigido a contextualizar el riesgo y reforzar el conocimiento público sobre la enfermedad.
Actuar con rapidez
Según García, una de las claves para contener estos episodios es la identificación rápida de contactos estrechos. “Lo importante es hacer una buena historia clínica y localizar a las personas que han tenido contacto cercano para administrar profilaxis antibiótica preventiva y cortar la transmisión”, subraya.
Uno de los principales retos de la enfermedad meningocócica es que sus síntomas iniciales pueden confundirse con infecciones comunes, como la gripe. Entre los signos más frecuentes se encuentran fiebre alta repentina, dolor de cabeza intenso, rigidez de cuello, vómitos y sensibilidad a la luz. También pueden aparecer somnolencia intensa, confusión o dificultad para despertar.
En los cuadros más graves pueden aparecer en la piel las citadas petequias, que no desaparecen al presionarlas, un signo que debe hacer sospechar una infección grave y requiere atención médica urgente.
El tratamiento requiere la administración inmediata de antibióticos en el ámbito hospitalario, que suelen iniciarse incluso antes de confirmar el diagnóstico cuando la sospecha es alta. Además del tratamiento individual, las estrategias de salud pública se centran en cortar la transmisión mediante la profilaxis antibiótica preventiva a contactos estrechos, como se ha hecho en el Reino Unido, donde miles de personas han recibido tratamiento preventivo.
Brotes como el ocurrido en Kent generan inquietud social pero, como resume García, el riesgo general para la población sigue siendo bajo. No obstante, la gravedad potencial de la enfermedad obliga a mantener sistemas de vigilancia epidemiológica sólidos, programas de vacunación eficaces y una comunicación clara con la ciudadanía.
Por: Aser G. Rada | Agencia SINC